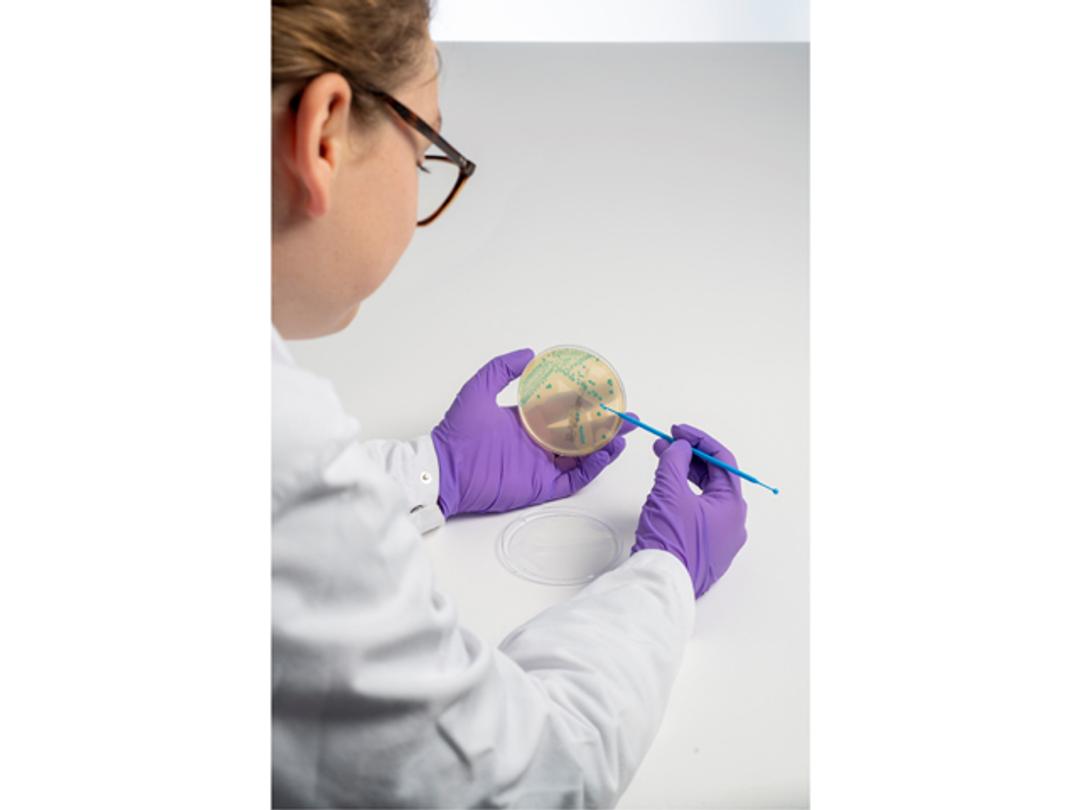
Thermo Scientific Precis Methods

Thermo Scientific™ Precis™ Methods
Next generation culture media technology for food testing: Thermo Scientific™ Precis™ Methods have been expertly designed to overcome sensitivity and specificity issues without the need to carry out non-standard steps. Offering multiple benefits in handling, performance, and time to result, the workflows help laboratories to streamline testing, save costs and provide more accurate rapid results - first time.

The supplier does not provide quotations for this product through SelectScience. You can search for similar products in our Product Directory.
Thermo Scientific™ Precis™ Methods provide faster workflows for key foodborne pathogens: Salmonella species, Cronobacter species, Listeria species and Listeria monocytogenes. All follow the principal of a single overnight enrichment, a single chromogenic agar plate and a single, simple confirmation step. Compared to traditional culture-based methods, Precis Methods are simpler to run and generate results within a two-day timeframe, enabling quicker actions and shorter product hold times.
Benefit from:
- One plate delivering right first-time results thanks to highly distinguishable, colored colonies
- One 10 uL microbiological loop for all sample types
- Reduced plate inoculation time
- One incubation temperature
- One easy confirmation step
Brochures
Thermo Scientific Precis Methods
In this product brochure, Thermo Fisher Scientific demonstrates the Thermo Scientific™ Precis™ Methods, which has been expertly designed to overcome sensitivity and specificity issues without the need to carry out non-standard handling steps.
Food microbiology testing methods: Salmonella species
Effective detection and confirmation methods for Salmonella are crucial for public health and food safety. In this guide, Thermo Fisher Scientific illustrates a simple outline of the ISO reference method: ISO 6579-1:2017 (Horizontal method for the detection of Salmonella species), including information about Thermo Scientific products that can be used according to the method. The guide also details alternative methods, validated according to ISO 16140-2:2016 standard, that are available from Thermo Fisher Scientific.
How to navigate the food regulatory landscape for Listeria spp. and Listeria mono. testing
Friday, November 21, at 13:00 GMT | 14:00 CET | 08:00 EST | 05:00 PST
Listeriosis remains a serious public health concern. In 2023, thirty EU/EEA countries reported 2,993 confirmed cases, the highest annual total since surveillance began. In the U.S., around 1,250 cases occur each year, leading to approximately 1,070 hospitalizations. Between 2016 and 2023, a multi-country cluster linked to ready-to-eat foods resulted in 64 cases across five EU/EEA countries
These persistent outbreaks continue to challenge food producers worldwide and in response to this, regulatory requirements globally have been rapidly evolving in recognition of these threats. Remaining compliant in this fast-changing landscape adds further complexity for testing laboratories.
Regulatory bodies have responded to these threats with revisions and tightening of the current regulatory frameworks for Listeria spp. and L. monocytogenes:
- FSIS broadened its testing to include non‑Listeria monocytogenes species from January 17, 2025.
- EU Regulation 2024/2895 sets a '0 cfu/25 g' requirement for Listeria in ready‑to‑eat foods.
Register for this exclusive webinar to hear from microbiology experts, Katharine Evans, François Le Nestour and Dr. Salman Zeitouni as as they discuss how labs can stay ahead by adopting internal standards that exceed minimum regulatory requirements and by implementing robust, adaptable pathogen‑testing programs.
Key learning objectives:
- Uncover the fundamentals of Listeria and its pathogenicity
- Review major Listeria outbreaks and their human impact
- Decode recent regulatory changes from the US and EU on Listeria
- Learn how to design and validate testing protocols that go beyond minimum regulatory requirements, ensuring continuity when regulations change
- Explore Thermo Fisher Scientific's microbiology solutions for rapid detection and enumeration of Listeria and Listeria spp.
Who should attend?
- Food testing professionals
Certificate of attendance
If you attend the live webinar, you will automatically receive a certificate of attendance, including a learning outcomes summary, for continuing education purposes.
If you view the on-demand webinar, you can request a certificate of attendance by emailing editor@selectscience.net.